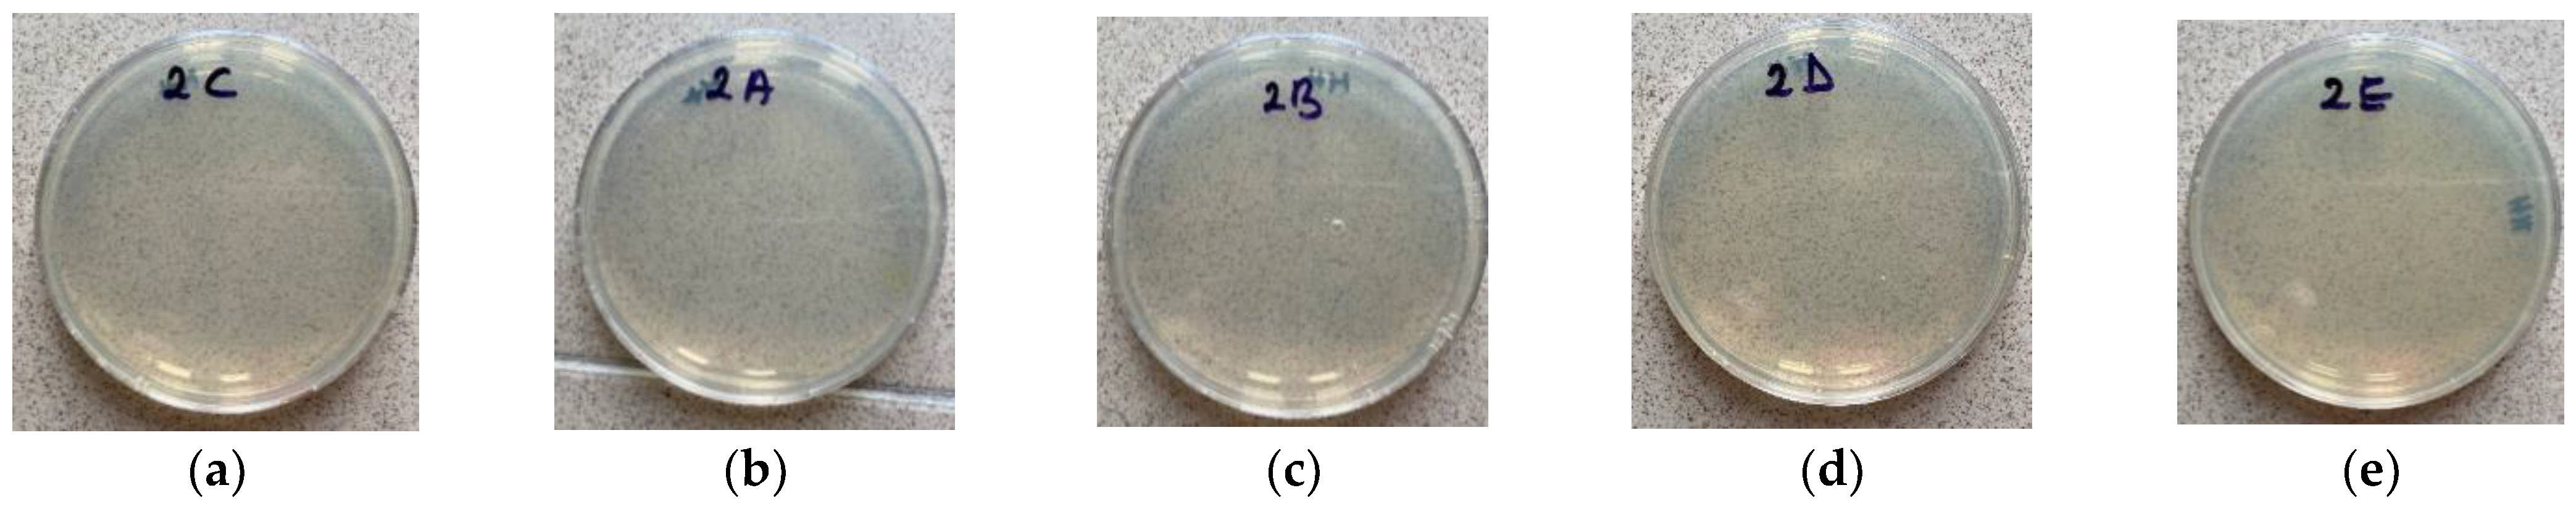
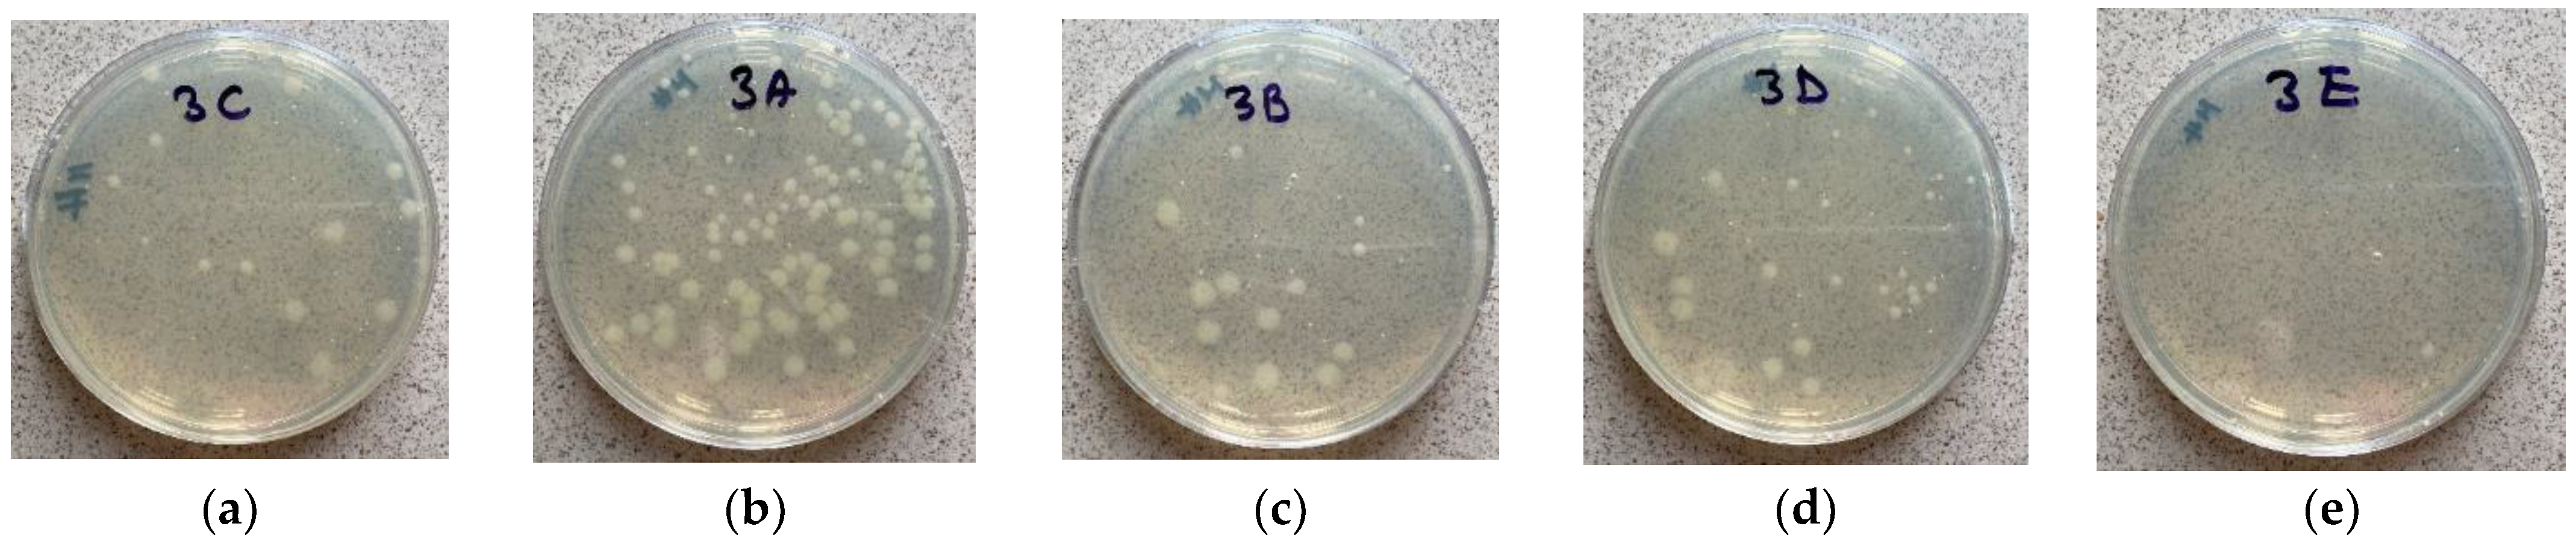

The Efficacy of Three Types of Disinfectants on the Microbial Flora from the Surface of Impression Materials Used in Dentistry—In Vitro Study
Abstract
1. Introduction
2. Materials and Methods
3. Results
4. Discussion
- In vivo conditions could not be reproduced perfectly. The presence of saliva, blood, dental plaque, and gingival fluids were not taken into account.
- The smaller size and different form of the specimens, compared with an in vivo impression, can lead to different results, especially when the disinfection is carried out by spraying.
- The study was performed by examining the bacterial load of the impressions for three species of microorganisms: Staphylococcus aureus, Pseudomonas aeruginosa, and Candida albicans.
5. Conclusions
- Rinsing dental impressions with tap water leaves a considerable microbial load on the surface of the impression materials.
- The surface disinfectant tested is not effective for disinfecting dental impressions. These findings require further in-vivo examination to elucidate the disinfection efficacy in cases of other types of microorganisms from the oral cavity’s bacterial flora and the disinfectants’ effect on the dimensional stability of the impressions.
Author Contributions
Funding
Institutional Review Board Statement
Informed Consent Statement
Data Availability Statement
Acknowledgments
Conflicts of Interest
References
- Bäckhed, F.; Fraser, C.M.; Ringel, Y.; Sanders, M.E.; Sartor, R.B.; Sherman, P.M.; Finlay, B.B. Defining a healthy human gut microbiome: Current concepts, future directions, and clinical applications. Cell Host Microbe. 2012, 12, 611–622. [Google Scholar] [CrossRef] [PubMed]
- Wade, W.G. The oral microbiome in health and disease. Pharm. Res. 2013, 69, 137–143. [Google Scholar] [CrossRef] [PubMed]
- Chidambaranathan, A.S.; Balasubramanium, M. Comprehensive review and comparison of the disinfection techniques currently available in the literature. J. Prosthodont. 2019, 28, e849–e856. [Google Scholar] [CrossRef] [PubMed]
- Mantena, S.R.; Mohd, I.; Sajjan, S.; Ramaraju, A. Disinfection of impression materials: A comprehensive review of disinfection methods. IJDM 2019, 1, 7–16. [Google Scholar] [CrossRef]
- Mohapatra, S. Sterilization and Disinfection. In Essentials of Neuroanesthesia; Academic Press: Cambridge, MA, USA, 2017; pp. 929–944. [Google Scholar] [CrossRef]
- Al Mortadi, N.; Al-Khatib, A.; Alzoubi, K.H.; Khabour, O.F. Disinfection of dental impressions: Knowledge and practice among dental technicians. Clin. Cosmet. Investig. Dent. 2019, 11, 103–108. [Google Scholar] [CrossRef]
- Cottone, J.A.; Young, J.M.; Dinyarian, P. Disinfection/Sterilization Protocols recommended by Manufacturers of Impression Materials. Int. J. Prosthodont. 1990, 3, 379–383. [Google Scholar]
- Hemalatha, R.; Ganapathy, D. Disinfection of dental impression—Acurrent overview. Int. J. Pharm. Sci. Res. 2016, 8, 661–664. [Google Scholar]
- Scully, C.; Griffiths, M.; Levers, H.; Blake, C.; Chartres, L. The control of cross-infection in UK clinical dentistry in the 1990s: Immunisation against hepatitis B. Br. Dent. J. 1993, 174, 29–31. [Google Scholar] [CrossRef]
- Ghasemi, E.; Badrian, H.; Hosseini, N.; Khalighinejad, N. The effect of three different disinfectant materials on polyether impressions by spray method. World J. Dent. 2012, 3, 229–233. [Google Scholar] [CrossRef]
- Sree lakshmi, S.B.; Somasundram, J.; Geetha, R.V. Disinfection of impression material—A review. Eur. J. Mol. Clin. Med. 2020, 7, 2451–2460. [Google Scholar]
- Tenover, F.C. Antimicrobial Susceptibility Testing. In Encyclopedia of Microbiology, 4th ed.; Schmidt, T.M., Ed.; Academic Press: Cambridge, MA, USA, 2019; pp. 166–175. ISBN 9780128117378. [Google Scholar] [CrossRef]
- Mueller, J.H.; Hinton, J. A protein-free medium for primary isolation of the Gonococcus and Meningococcus. Proc. Soc. Exp. Biol. Med. 1941, 48, 330–333. [Google Scholar] [CrossRef]
- Akinpelu, D.A.; Abioye, E.O.; Aiyegoro, O.A.; Akinpelu, O.F.; Okoh, A.I. Evaluation of Antibacterial and Antifungal Properties of Alchornea laxiflora (Benth.) Pax. Hoffman. Evid. Based Complement. Altern. Med. 2015, 2015, 684839. [Google Scholar] [CrossRef]
- Tille, P.M. Bailey & Scott’s Diagnosis Microbiology, 13th ed.; Elsevier Mosby: St. Louis, MO, USA, 2014; pp. 39–41. [Google Scholar]
- Department of Health. Decontamination in Primary Care Dental Practices. In Health Technical Memorandum 01-05; Department of Health: London, UK, 31 March 2013. [Google Scholar]
- Azevedo, M.J.; Correia, I.; Portela, A.; Sampaio-Maia, B. A simple and effective method for addition silicone impression disinfection. J. Adv. Prosthodont. 2019, 11, 155–161. [Google Scholar] [CrossRef] [PubMed]
- Hardan, L.; Bourgi, R.; Cuevas-Suárez, C.E.; Lukomska-Szymanska, M.; Cornejo-Ríos, E.; Tosco, V.; Monterubbianesi, R.; Mancino, S.; Eid, A.; Mancino, D.; et al. Disinfection Procedures and Their Effect on the Microorganism Colonization of Dental Impression Materials: A Systematic Review and Meta-Analysis of In Vitro Studies. Bioengineering 2022, 9, 123. [Google Scholar] [CrossRef] [PubMed]
- Al Shikh, A.; Milosevic, A. Effectiveness of Alcohol and Aldehyde Spray Disinfectants on Dental Impression. Clin. Cosmet. Investig. Dent. 2020, 12, 25–30. [Google Scholar] [CrossRef] [PubMed]
- Gupta, S.; Rani, S.; Garg, S. Infection control knowledge and and practice: A cross-sectional survey on dental laboratories in dental institutes of North India. J. Indian Prosthodont. Soc. 2017, 17, 348–354. [Google Scholar]
- Wezgowiec, J.; Wieczynska, A.; Wieckiewicz, M.; Czarny, A.; Malysa, A.; Seweryn, P.; Zietek, M.; Paradowska-Stolarz, A. Evaluation of Antimicrobial Efficacy of UVC Radiation, Gaseous Ozone, and Liquid Chemicals Used for Disinfection of Silicone Dental Impression Materials. Materials 2022, 15, 2553. [Google Scholar] [CrossRef]
- Demajo, J.K.; Cassar, V.; Farrugia, C.; Millan-Sango, D.; Sammut, C.; Valdramidis, V.; Camilleri, J. Effectiveness of Disinfectants on Antimicrobial and Physical Properties of Dental Impression Materials. Int. J. Prosthodont. 2016, 29, 63–67. [Google Scholar] [CrossRef]
- Samra, R.K.; Bhide, S.V. Comparative evaluation of dimensional stability of impression materials from developing countries and developed countries after disinfection with different immersion disinfectant systems and ultraviolet chamber. Saudi Dent. J. 2018, 30, 125–141. [Google Scholar] [CrossRef]
- Ulgey, M.; Gorler, O.; Yesilyurt, G. Importance of disinfection time and procedure with different alginate impression products to reduce dimensional instability. Niger. J. Clin. Pract. 2020, 23, 288. [Google Scholar]
- Giammanco, G.M.; Melilli, D.; Rallo, A.; Pecorella, S.; Mammina, C.; Pizzo, G. Resistance to dezinfection of polymicrobial association contaminating the surface of elastomeric dental impression. New Microbiol. 2009, 32, 167–172. [Google Scholar] [PubMed]
- Hussein, A.; Mahross, H.; Shiko, S. Evaluation of dimensional accuracy for different complete edentulous impression immersed in different disinfectant solution. Eur. J. Dent. 2017, 11, 242–249. [Google Scholar]
- Asopa, S.J.; Padiyar, U.N.; Verma, S.; Suri, P.; Somayaji, N.S.; Radhakrishnan, I.C. Effect of heat sterilization and chemical method of sterilization on the polyvinyl siloxane impression material. A comparative study. Fam. Med. Prim. Care. Rev. 2020, 9, 1348–1353. [Google Scholar] [CrossRef] [PubMed]
- Mahalakshmi, A.S.; Jeyapalan, V.; Mahadevan, V.; Krishnan, C.S.; Azhagarasan, N.S.; Ramakrishnan, H. Comparative evaluation of the effect of electrolyzed oxidizing water on surface detail reproduction, dimensional stability and Surface texture of poly vinyl siloxane impressions. J. Indian Prosthodont. Soc. 2019, 19, 33–41. [Google Scholar]
- Kavita, K.; Reddy, K.R.P.; Reddy, K.R.M.; Kumar, S.; Pandey, G.; Singh, R. Assessment of Effect of Different Sterilization Agents on Dimensional Accuracy of Different Impression Materials in Implant Prosthesis—An In vitro Study. J. Pharm. Bioallied. Sci. 2021, 13, S1620–S1623. [Google Scholar] [CrossRef]
- Jeyapalan, V.; Krishnan, C.S.; Ramasubramanian, H.; Sampathkumar, J.; Azhagarasan, N.S.; Krishnan, M. Comparative Evaluation of the Antimicrobial Efficacy of Three Immersion Chemical Disinfectants on Clinically Derived Poly(Vinyl Siloxane) Impressions. J. Prosthodont. 2018, 27, 469–475. [Google Scholar] [CrossRef]
- Celebi, H.; Büyükerkmen, E.B.; Torlak, E. Disinfection of polyvinyl siloxane impression material by gaseous ozone. J. Prosthet. Dent. 2018, 120, 138–143. [Google Scholar] [CrossRef]
- Choi, Y.R.; Kim, K.N.; Kim, K.M. The disinfection of impression materials by using microwave irradiation and hydrogen peroxide. J. Prosthet. Dent. 2014, 112, 981–987. [Google Scholar] [CrossRef]
- Choi, Y.-R.; Yoo, E.-M.; Seo, H.-Y.; Kang, M.-K. Surface Characterization, Antimicrobial Activity of Nonthermal Atmospheric-Pressure Plasma Jet on Polyvinyl Siloxane Impression Materials. Medicina 2022, 58, 1556. [Google Scholar] [CrossRef]

| Impression Materials | Type | Consistency | Delivery System | Clinical Working Time (min:s) | Time in the Mouth (min:s) | Setting Time (min:s) |
|---|---|---|---|---|---|---|
| Tropicalgin | Alginate | - | Manual mixing | 1:35 | 1:00 | 2:35 |
| Zetaplus | C-silicone | Putty | Manual mixing | 1:15 | 3:30 | 4:45 |
| Oranwash L | C-silicone | Light-body | Manual mixing | 1:30 | 3:30 | 5:00 |
| Elite HD+ Putty Soft | A-silicone | Putty | Manual mixing | 2:00 | 3:30 | 5:30 |
| Elite HD+ Light Body | A-silicone | Light-body | Dispenser gun | 2:00 | 3:30 | 5:30 |
| Disinfectants | Application | Active Ingredients/100 g | Action Time (Minutes) | Spectrum of Action |
|---|---|---|---|---|
| Zeta 3 Soft | Ready-to-use spray | Alcohols (34.4 g ethanol, 14 g isopropanol) | 1–5 | Bactericidal: EN 13727, EN 14561 (Staphylococcus aureus, Pseudomonas aeruginosa) Yeasticidal: EN 13624, EN 14562 (Candida albicans) Tuberculocidal: EN 14348, EN 14563 Virucidal: EN 14476 |
| Zeta 7 Spray | Ready-to-use spray | Alcohols (83 g ethanol, 10 g 2-propanol) | 3 | Bactericidal: EN13727 (Staphylococcus aureus, Pseudomonas aeruginosa) Yeasticidal: EN 13624 (Candida albicans) Tuberculocidal: EN 14348, EN 14563 Virucidal: EN 14476 |
| Zeta 7 Solution | Concentrated solution (recommended dilution 1%) | Quaternary ammonium salts, Phenoxyethanol (7.7 g dimethyl-didecyl-ammonium chloride, 15 g phenoxyethanol) | 10 | Bactericidal: EN13727 (Staphylococcus aureus, Pseudomonas aeruginosa) Yeasticidal: EN 13624 (Candida albicans) Tuberculocidal: EN 14348 Virucidal: EN 14476 |
| Microorganisms | Type | Shape | Frequently Found |
|---|---|---|---|
| Staphylococcus aureus | Gram-positive bacteria | Spherical-shaped | Upper respiratory tract, skin |
| Pseudomonas aeruginosa | Gram-negative bacteria | Rod-shaped | Soil, water, skin |
| Candida albicans | Fungi | Gastrointestinal tract, mouth |
| Tropicalgin | Zetaplus | Oranwash L | Elite HD + Putty Soft | Elite HD + Light Body | |
|---|---|---|---|---|---|
| Minimum | 161.0 | 180.0 | 191.0 | 200.0 | 20.0 |
| Median | 215.0 | 214.0 | 192.0 | 212.0 | 206.0 |
| Maximum | 218.0 | 225.0 | 203.0 | 212.0 | 225.0 |
| Mean | 198.0 | 206.3 | 195.3 | 208.0 | 210.7 |
| Std. Deviation | 32.08 | 23.46 | 6.658 | 6.928 | 12.66 |
| Lower 95% CI of mean | 118.3 | 148.1 | 178.8 | 190.8 | 179.2 |
| Upper 95% CI of mean | 277.7 | 264.6 | 211.9 | 225.2 | 242.1 |
| Impression Materials | Disinfectants | Minimum | Median | Maximum | Mean | Std. Deviation | Lower 95% CI of Mean | Upper 95% CI of Mean |
|---|---|---|---|---|---|---|---|---|
| Tropicalgin | Zeta 7 Spray | 7 | 10 | 13 | 10 | 2 | 8.569 | 11.43 |
| Zeta 7 Solution | 0 | 2 | 4 | 2 | 1.247 | 1.108 | 2.892 | |
| Zeta 3 Soft | 22 | 36 | 50 | 36 | 7.087 | 30.93 | 41.07 | |
| Zetaplus | Zeta 7 Spray | 3 | 5 | 7 | 5 | 1.491 | 3.934 | 6.066 |
| Zeta 7 Solution | 0 | 2 | 4 | 2 | 1.247 | 1.108 | 2.892 | |
| Zeta 3 Soft | 68 | 92.5 | 114 | 92 | 11.13 | 84.04 | 99.96 | |
| Oranwash L | Zeta 7 Spray | 1 | 3 | 5 | 3 | 1.491 | 1.934 | 4.066 |
| Zeta 7 Solution | 0 | 0 | 0 | 0 | 0 | 0 | 0 | |
| Zeta 3 Soft | 20 | 31 | 40 | 30 | 5.395 | 26.14 | 33.86 | |
| Elite HD + Putty Soft | Zeta 7 Spray | 0 | 2.5 | 8 | 3 | 2.582 | 1.153 | 4.847 |
| Zeta 7 Solution | 0 | 0.5 | 4 | 1 | 1.333 | 0.04619 | 1.954 | |
| Zeta 3 Soft | 30 | 49 | 68 | 49 | 14.5 | 38.63 | 59.37 | |
| Elite HD + Light Body | Zeta 7 Spray | 0 | 1 | 3 | 1 | 1.054 | 0.2459 | 1.754 |
| Zeta 7 Solution | 0 | 0 | 0 | 0 | 0 | 0 | 0 | |
| Zeta 3 Soft | 4 | 11.5 | 21 | 12 | 5.437 | 8.111 | 15.89 |
| Zeta 7 Spray vs. Zeta 7 Solution | Zeta 7 Spray vs. Zeta 3 Soft | Zeta 7 Solution vs. Zeta 3 Soft | |
|---|---|---|---|
| p Value | |||
| Tropicalgin | 0.0329 * | 0.0329 * | <0.0001 **** |
| Zetaplus | 0.0746 | 0.0206 * | <0.0001 * |
| Oranwash L | 0.0288 * | 0.0288 * | <0.0001 * |
| Elite HD + Putty Soft | 0.601 | 0.0041 ** | <0.0001 * |
| Elite HD + Light Body | 0.323 | 0.0039 ** | <0.0001 * |
Disclaimer/Publisher’s Note: The statements, opinions and data contained in all publications are solely those of the individual author(s) and contributor(s) and not of MDPI and/or the editor(s). MDPI and/or the editor(s) disclaim responsibility for any injury to people or property resulting from any ideas, methods, instructions or products referred to in the content. |
© 2023 by the authors. Licensee MDPI, Basel, Switzerland. This article is an open access article distributed under the terms and conditions of the Creative Commons Attribution (CC BY) license (https://creativecommons.org/licenses/by/4.0/).
Share and Cite
Cerghizan, D.; Jánosi, K.M.; Ciurea, C.N.; Popelea, O.; Baloș, M.D.; Crăciun, A.E.; Hănțoiu, L.G.; Albu, A.I. The Efficacy of Three Types of Disinfectants on the Microbial Flora from the Surface of Impression Materials Used in Dentistry—In Vitro Study. Appl. Sci. 2023, 13, 1097. https://doi.org/10.3390/app13021097
Cerghizan D, Jánosi KM, Ciurea CN, Popelea O, Baloș MD, Crăciun AE, Hănțoiu LG, Albu AI. The Efficacy of Three Types of Disinfectants on the Microbial Flora from the Surface of Impression Materials Used in Dentistry—In Vitro Study. Applied Sciences. 2023; 13(2):1097. https://doi.org/10.3390/app13021097
Chicago/Turabian StyleCerghizan, Diana, Kinga Mária Jánosi, Cristina Nicoleta Ciurea, Oana Popelea, Monica Dora Baloș, Adriana Elena Crăciun, Liana Georgiana Hănțoiu, and Aurița Ioana Albu. 2023. "The Efficacy of Three Types of Disinfectants on the Microbial Flora from the Surface of Impression Materials Used in Dentistry—In Vitro Study" Applied Sciences 13, no. 2: 1097. https://doi.org/10.3390/app13021097
APA StyleCerghizan, D., Jánosi, K. M., Ciurea, C. N., Popelea, O., Baloș, M. D., Crăciun, A. E., Hănțoiu, L. G., & Albu, A. I. (2023). The Efficacy of Three Types of Disinfectants on the Microbial Flora from the Surface of Impression Materials Used in Dentistry—In Vitro Study. Applied Sciences, 13(2), 1097. https://doi.org/10.3390/app13021097

